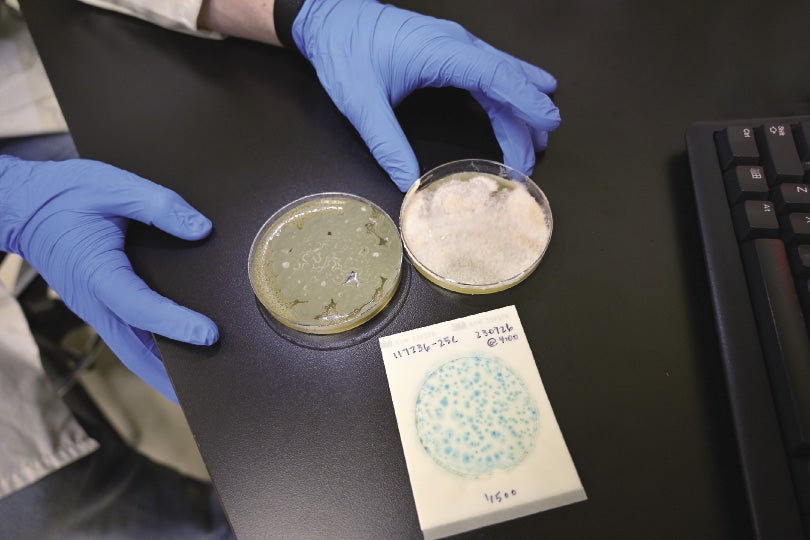

EDITOR’S NOTE: This article was updated on Feb. 7 to include more information on the lawsuit and details about the history of cannabis testing in Massachusetts.
The controversy surrounding Massachusetts cannabis testing practices and labs has spilled over into the courts, as Framingham-based MCR Labs has filed a lawsuit against nine competitors, saying their alleged manipulation of testing results is causing harm to both consumers and MCR’s business.
The lawsuit cites WBJ’s investigation into dysfunction at the state agency Cannabis Control Commission, referencing the fact Julie Johnson, the agency’s chief of research, said when she was eventually able to obtain testing data from the agency, it showed a large amount of samples fell just below the state’s threshold for contaminants, something she said was a near statistical impossibility.
The 50-page lawsuit, filed in Suffolk County Superior Court on Jan. 30, claims the actions of the labs has violated state law, intentionally interfered with MCR’s business relations, and led to unjust enrichment.
“Despite the regulatory requirements, the rigors of accepted and accredited testing procedures, and the fact that the true THC potency and presence of contaminants are determinable with accuracy using validated testing methods, defendant labs have demonstrated their willingness to provide more favorable results — regardless of their empirical fallaciousness — in order to tempt customers away from other labs, namely plaintiff,” the lawsuit reads.
Citing data MCR obtained through records requests, the firm notes what it says are clear examples of fraud.
“Honest and accurate testing is essential for consumer safety, public health, and a fair and prosperous market,” MCR wrote in a Jan. 31 press release accompanying a copy of the lawsuit. “Fraudulent testing practices harm patients, consumers, industry workers, and ethical businesses. We have fought against widespread result manipulation in the cannabis industry for years.”
Johnson told WBJ in October she tried in vain for years to obtain testing data from the agency but was rebuffed. Then, at a science-themed cannabis event hosted by MCR she attended in December 2023, she was shocked when one speaker presented a thorough analysis of the very data she had sought, accessed via a public record request. That data now serves as the basis for many of MCR’s claims and appears to show CCC had access to data showing probable fraud for years, but took little action.

Eight labs named
MCR alleges some of its defendants participated in round robins, when a cannabis cultivator or product manufacturer sends samples from the same product to multiple labs at once. MCR claims this is done in order to see which one provides the most favorable result, encouraging firms to inflate potency numbers and pass samples that would otherwise fail containment testing.
The lawsuit names eight cannabis testing labs as defendants:
• Analytics Labs, in Holyoke
• Assured Testing Laboratories, in Tyngsborough
•CDX Analytics, a Salem-based lab closed in 2024
•Green Analytics, in Framingham (formerly known as Steep Hill Massachusetts)
• Green Valley Analytics, in Holyoke
• Kaycha Labs, in Natick
• Massbiolytics Corp., in Dracut
• Safetiva Labs, in Westfield
For each of the defendants named by MCR, the lawsuit includes data which MCR says it obtained from the state through public records requests and shows examples of fraud.

A graph depicting one cultivator’s transition from using MCR for testing to Green Valley Analytics shows the firm’s THC testing results – used to measure product potency – increased 46.3% after the switch. Another graph shows a MCR client who switched their testing to CDX Analytics saw their mold failure go from 9.4% to zero.
MCR claims CDX was particularly well known in the industry for having low failure rates before its closure.
The lawsuit states in the summer of 2023, a concerned consumer sent a sample of product to Milford testing firm ProVerde Laboratories after spotting what appeared to be mold on the cannabis. After the product failed mold testing and the consumer posted the results on social media, CDX’s overall failure rate shot up from 3.3% to 28.1%, according to MCR’s analysis of state data.
CDX and five other firms did not respond to WBJ’s requests for comment.When reached by WBJ by email, Green Valley Analytics declined to comment.
There are 15 cannabis testing laboratories licensed to operate in the state, according to CCC data. However, not all of them are operational; Marlborough-based Indo Laboratories closed in September, with a LinkedIn post by former Indo Lab Director Chuck Kreiman blaming clients’ financial struggles.
“It couldn’t pay its bills because the clients couldn’t or wouldn’t pay their own bills, and the owners/investors were tired of subsidizing the clientele,” he wrote. “The legal cannabis industry here in Mass. has some pretty severe structural problems right now.”
ProVerde Laboratories, which has sounded the alarm regarding the state’s testing space, is not a defendant in the case and has also been vocal about the problems it faces. Peter Ianuzzi, CEO of ProVerde, told WBJ in 2023 state regulators were asleep at the wheel.
“The biggest problem is that nobody is looking,” Ianuzzi said.
Persistent pot problems
In October, an investigation from the Wall Street Journal found from April 2021 through 2023 labs in Massachusetts that failed fewer tests than other labs in the previous year tested a median of 84% more samples during the following 12 months, suggesting growers were seeking out labs likely to approve products.
CCC told WSJ environmental factors and different testing methods can produce atypical results. However, accusations of fraud and businesses shopping between labs to get more desirable testing results have been common knowledge in industry circles for years.
Lab employees and others in the cannabis industry have long lamented the state of cannabis testing regulations and enforcement in Massachusetts, with MCR executives telling lawmakers in July 2023 that fraud and abuse were rampant in the space, according to State House News Service.
Problems have arisen with product safety beyond issues with testing methods themselves; an audit conducted in September 2023 by Massachusetts State Auditor Diana DiZoglio found Cannabis Control Commission had allowed more than $10 million in marijuana products whose testing approvals had expired to be sold to consumers.
CCC sought to tighten its testing requirements in December, issuing an administrative order which attempted to clarify existing testing protocols by telling cannabis businesses they may only submit one test sample package to a single testing lab for all compliance-related testing, according to an agency press release.
This move sought to end the practice of lab shopping, where cultivators and manufacturers seek out labs with high potency results and low failure rates.
Eric Casey is the managing editor at Worcester Business Journal, who primarily covers the manufacturing and real estate industries.